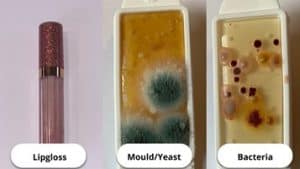

With more people than ever taking an interest in makeup due to platforms such as TikTok showcasing new trends and hacks, it’s essential that makeup users are aware of the bacteria that could be harbouring on their most loved brushes if they aren’t cleaned regularly and correctly.
Our new research reveals the dirtiest items in a makeup bag and highlights how much bacteria is lurking on our most-used makeup brushes.
To prove just how often makeup brushes should be cleaned, we swabbed¹ the most common brushes found in a makeup bag to test for aerobic bacteria, yeast and mould. The swabs were then incubated and tested to find the number of colony-forming units per cm2, revealing the worst makeup brushes for high levels of viable bacteria and fungal cells.
The dirtiest makeup brushes according to our study are:
- Eyeshadow brush (928 combined colony forming units)
- Blusher brush (697.5 combined colony forming units)
- Lipgloss (625 combined colony forming units)
- Eyelash curler (601.2 combined colony forming units)
- Beauty blender (521 combined colony forming units)
- Fake tan mitt (376.4 combined colony forming units)
- Concealer blender (207 combined colony forming units)
- Eyebrow spoolie (98 combined colony forming units)
- Eyeliner (95 combined colony forming units)
- Mascara brush/wand (92.5 combined colony forming units)
- Foundation brush (85.5 combined colony forming units)
Eyeshadow brush
The study by our team of skin specialists, found that the eyeshadow brush is the worst offending item in a makeup bag, ranking the highest of all the tested areas for yeast colonies per agar² – a staggering 600. The level of mould identified on the eyeshadow brush (60) also outranked all other brushes tested.
It’s important to be aware that unclean brushes that come into contact with the eye could increase the chances of contracting an eye infection, which could cause swelling of the eyelid, discharge, inflammation of the white of the eye, and itchiness.

Blusher brush
Used to add a pop of colour to the face, the blusher brush is the second dirtiest brush found in the makeup bag due to high levels of bacteria colonies per agar³ (500) and harbouring a high infection level (100). Due to having direct contact with the main parts of the face, a bacteria-infested blusher brush could clog pores and lead to an acne breakout. It could also cause a breakdown of collagen, subsequently leading to premature ageing.

Lipgloss
Used on almost every night out and known to be passed around from friend to friend, the lip gloss container and the applicator are the third dirtiest item found in a makeup bag. A staggering 400 colonies of bacteria were present on the swab sample of the lip gloss, alongside high levels of infection (100) and mould (50).
Eyelash curler
Another tool that has direct contact with the eye is the eyelash curler, ranking fourth on the list for having the most colony-forming units, including a whopping 540 colonies of bacteria and a level of infection of 60. Unclean eyelash curlers are a danger to the eye, with the tool so close to the eye itself, there is a chance of an eye infection which could lead to further damage.

Beauty blender
After the eyelash curler, the beauty blender ranks fifth as the dirtiest makeup applicator. The worst colony-forming units on the beauty blender include colonies of yeast (85) and colonies of bacteria (35). Using an unclean beauty blender is extremely harmful to the skin and is likely to cause acne, skin infections and possibly even e.coli.
Unhygienic beauty blenders have been gaining lots of attention on social media recently, with many people sharing videos of cutting open their beauty blenders to find hidden mould.

Fake tan mitt
Coming in at six is the fake tan mitt, with a whopping 300 bacteria colonies per agar and a high level of infection (70). Using a dirty fake tan mitt can cause acne on the body due to the build-up of bacteria on the mitt, and the fake tan product is prone to causing clogged pores. A commonplace for acne to form is on your back, and if this occurs, we suggest using a gentle exfoliator and mitt to remove dead skin cells.
Concealer blender
Another beauty applicator with direct contact to the skin is the concealer blender, ranking in seventh place after the fake tan mitt. The worst colony-forming units on the concealer blender include yeast (120) and bacteria (45). Concealer is often used under the eye as a brightening agent. Therefore, a dirty concealer blender used in this area could cause cellulitis of the eye – an infection of the skin and tissues around the eye.

Eyebrow spoolie
An item used daily to brush your eyebrows, a spoolie is a tool commonly found in makeup bags. The eyebrow spoolie ranks eighth with a high number of bacteria colonies per agar (60) and a very high level of mould (3). It’s very common to contract acne on the face, and it’s also possible to find acne beneath your eyebrow hairs. The build-up of bacteria on the hairs could also cause clogged pores, and subsequently, ingrown hairs, which can be very painful to remove.

Eyeliner
Eyeliner also comes into close contact with the eye, and this makeup product ranks ninth on our new list. With many colonies of yeast (45) and bacteria (30), it’s clear to see how a dirty eyeliner applicator could cause eye irritation and possible infections. If you think you have an eye infection, we recommend talking to your GP to gather advice and the correct medication.

Mascara brush/wand
Mascara is one of the most popular items in a makeup bag. With millions using a mascara wand every day to elongate their lashes, it’s shocking to see the levels of bacteria it holds. The mascara brush ranks tenth on the list due to having numerous colonies of bacteria (60) and a high level of mould (3).

Foundation brush
Surprisingly, the foundation brush, arguably the most used out of every brush found in a makeup bag, produced the lowest amount of combined colony-forming units, with 85.5 in total. That’s a staggering 91% fewer bacteria, yeast and mould than found on the eyeshadow brush and 88% less than on the blusher brush.
Did you know unclean makeup brushes are dirtier than a toilet seat?
Even more surprising is that a toilet seat harbours an even lower amount of combined colony-forming units (3) than all 11 makeup brushes swabbed in our study. Overall, across the 11 brushes tested, the swabs found a total of 4,364 colonies of yeast and bacteria.

Our advice on washing your makeup brushes
It’s awful to see the number of bacteria that could potentially sit on a makeup brush. However, it’s not entirely shocking. Even after a person uses a makeup brush for the first time, it will already be forming colonies of bacteria.
With daily use, the brushes will automatically start collecting dirt, pollutants, oil and dead skin cells, which is why makeup brushes act as a breeding ground for bacteria which can lead to breakouts and skin irritations. If a contaminated brush comes into contact with the eye, this could cause infections or allergic reactions but these can be avoided with a weekly cleaning routine.
We recommend cleaning your makeup brushes at least once a week to avoid such an enormous build-up of bacteria. To clean the brushes properly, we suggest lathering the brush in an appropriate skin cleanser, massaging any bristles in the palm of your hand thoroughly, rinsing with lukewarm water and then squeezing the brush to remove any excess moisture. The more you clean your brushes, the less dirt seeps out of the bristles, but this is a good thing, so don’t stop cleaning your brushes regularly if you find this to be the case!
For more advice and insight, visit our blog.
Sources
- Swabs and incubator from ‘Dip Slides’ – swabs incubated at 30℃ for 48 hours.
- Yeast comparison chart
- Bacteria comparison chart




WHATSAPP